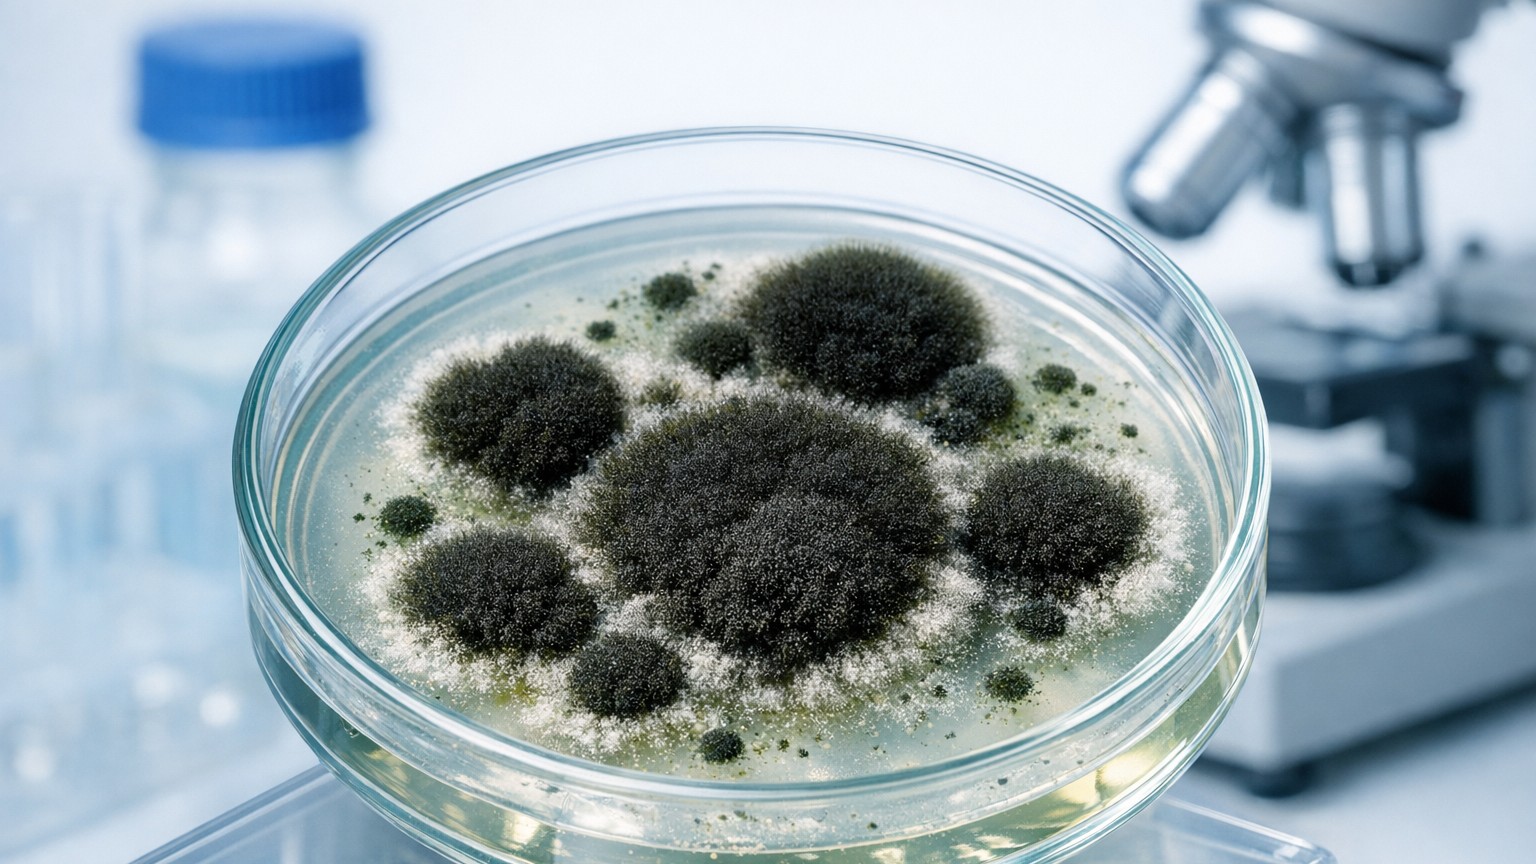
Dark mold growth on a wall

What People Mean by "Black Mold"
Most people mean Stachybotrys chartarum, a mold associated with chronic water damage. It can produce mycotoxins under certain conditions, but many common indoor molds also appear dark. Color is not a reliable indicator of risk.
The Real Concern
Mold exposure can cause health symptoms, especially for people with allergies, asthma, or weakened immune systems. The focus should be on fixing the moisture problem and proper remediation, not on species identification or panic. See our remediation guide and prevention guide for practical steps.
What You Should Do
If you see dark mold growth, focus on the basics and avoid fear-based decisions:
If you want more context on how "black mold" fits into the bigger picture, see our common indoor molds guide .